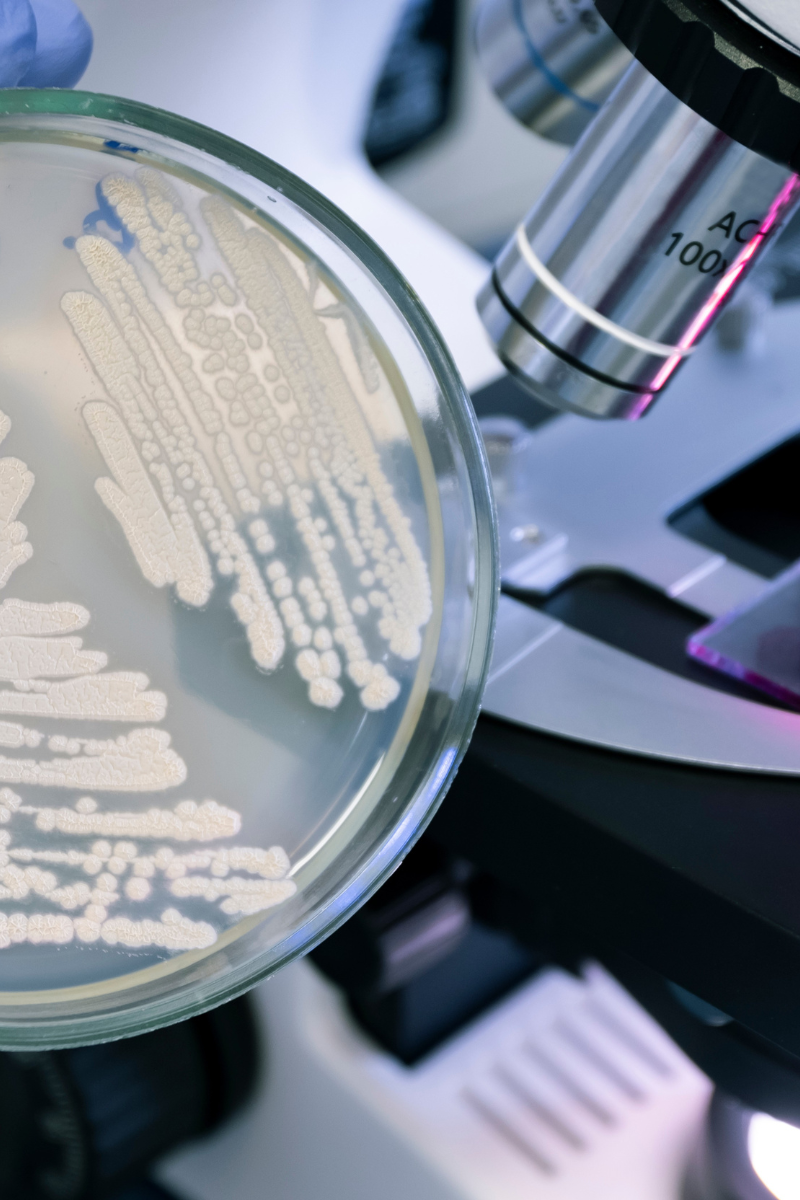

InfiniFerm
Unlocking antibiotic-and inducer-free continuous fermentation of bacteria through synthetic biology engineering.
About Us
Our Mission
For over 60 years, biomolecule expression has relied on the traditional approach of microbial biomass accumulation and transitioning to “production mode” using chemical inducers. This two-step process is wasteful, inefficient, and sensitive to genetic instabilities of producer organisms, ultimately reducing process productivity.
At InfiniFerm, a start-up from the University of Exeter, we revolutionize biomolecule expression by harnessing the power of synthetic biology to overcome the limitations of traditional two-step fermentation processes. Our mission is to transform this field by eliminating the need for antibiotics and chemical inducers once and for all. We are committed to creating a more sustainable and productive approach that maximizes process efficiency across industries and applications.
Key Features of the InfiniFerm Platform
Antibiotic-Free Platform
Regulation-ready compliance by eliminating the use of antibiotics and antimicrobial resistance (AMR) genes.
Inducer-Free Production
Achieves automatic, continuous expression of biomolecules without the need for chemical inducers.
Predictable Yields
Delivers reliable product yields for batch optimisation.
Maximal Efficiency
Increases process efficiency by continuously decoupling biomass growth from biomolecule production.
Customisable E. coli Platform
Offers flexible production setups tailored to specific project needs.
Seamless Integration
Easily integrates into existing batch fermentation systems for streamlined adoption.
The Next Generation High-Efficiency Microbial Production Platform
Our InfiniFerm platform transforms fermentation by leveraging advanced synthetic biology engineering to program bacteria to operate in a continuous growth and production mode.
By eliminating the need for costly and environmentally harmful chemical inducers and antibiotics, InfiniFerm offers a sustainable solution with seamless scalability.
Our platform provides predictable product yields while integrating with existing batch fermentation hardware, optimizing efficiency from lab to production scale.